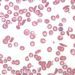
The REACH trial: hydroxyurea safe and effective for sickle cell anemia in African children

1. PPI use may be associated with an increased mortality risk in patients who have received kidney transplants.
Evidence Rating Level: 1 (Excellent)
Proton-pump inhibitors (PPIs) are commonly prescribed to kidney transplant recipients (KTRs) to protect against gastrointestinal symptoms and complications induced by their immunosuppressive therapy. Although PPIs are generally well-tolerated, numerous observational studies have demonstrated that chronic PPI use is associated with adverse health outcomes, such as increased nutritional deficiencies. A post hoc analysis of the TransplantLines Food and Nutrition Biobank and Cohort Study, a longitudinal study of American veterans (n= 349 312, median followup= 8.2years), found an increased mortality risk in PPI users compared to nonusers (n=703 KTRs, HR 1.86, P<0.001). This association remained independent after adjusting for potential confounding variables, such as medication use and comorbidities (HR 1.68, P=0.002). Specifically, PPI use was associated with an increased risk of mortality from cardiovascular causes (HR 2.42, P<0.001). Subgroup analyses also showed that this association appears to be dose dependent, with premature mortality highest in KTRs taking more than 20mg omeprazole equivalents/day (Ptrend<0.001). The results of their replication study, using an independent cohort of stable KTRS from University Hospitals Leuven (n=329, median followup= 3.7 years), showed similar results to those in the TransplantLines study. Prospective analyses showed PPI users had over twice the mortality risk of nonusers (HR 2.47, P<0.001), which remained significant after adjusting for potential confounders (HR 1.75, P=0.01). Further research is needed to fully elucidate whether there is a a cause-effect relationship between PPI use and its association with increased mortality risk in KTRs (i.e. conducting an RCT), and if it exists, by what mechanism.
Click to read the study in PLOS Medicine
©2020 2 Minute Medicine, Inc. All rights reserved. No works may be reproduced without expressed written consent from 2 Minute Medicine, Inc. Inquire about licensing here. No article should be construed as medical advice and is not intended as such by the authors or by 2 Minute Medicine, Inc.